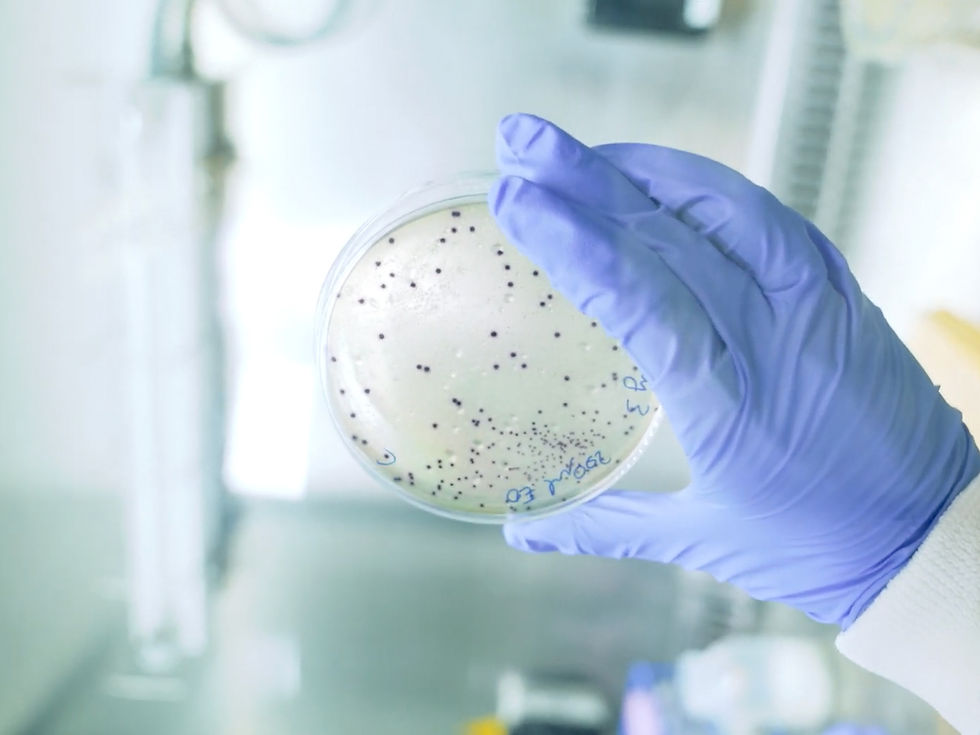
boobybiome microbiome research lab petri dish

Interview with Vitafoods Insights: BoobyBiome on Infant Health Innovation
- Booby Biome
- Feb 5
- 1 min read
Updated: Aug 20
London, 5 February 2025
BoobyBiome’s mission to deliver the benefits of the breast milk microbiome to every baby was recently spotlighted in an exclusive interview with Vitafoods Insights, the leading global platform for nutrition and health innovation.
In the feature, our co-founders Dr. Lydia Mapstone (CEO) and Dr. Sioned Fôn Jones (COO) shared insights into BoobyBiome’s journey - from building the world’s first breast milk microbiome database and biobank to developing products designed to support infant gut health.
Reflecting on the company’s ambitions, Dr. Sioned Jones said:
“In the next three to five years, we want to have two fully tested and clinically validated products on the market - the breast milk storage device and the synbiotic - and we want to make sure they are accessible to both parents and clinicians.”
Dr. Lydia Mapstone also spoke about the company’s long-term vision to clinically validate how restoring the breast milk microbiome could help prevent immune-related diseases such as asthma, allergies, and type 1 diabetes.
We are proud to be recognised by Vitafoods Insights for our work and vision, and we are excited to share our progress with their global audience.
Read the full interview here: UK biotech startup BoobyBiome wants every baby to receive crucial microbes
For more information about BoobyBiome and its mission, visit www.boobybiome.com.
Media Contact
Email: info@boobybiome.com
Phone: +447453310464

Comments